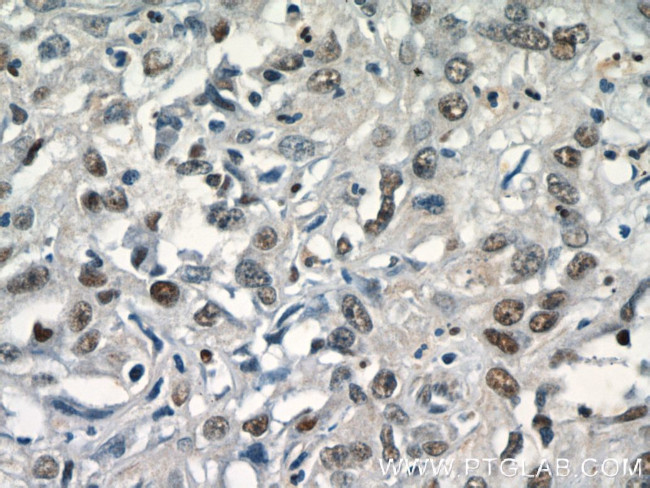
SGF29 Antibody in Immunohistochemistry (Paraffin) (IHC (P))

Search
Proteintech
SGF29 Polyclonal Antibody
{{$productOrderCtrl.translations['antibody.pdp.commerceCard.promotion.promotions']}}
{{$productOrderCtrl.translations['antibody.pdp.commerceCard.promotion.viewpromo']}}
{{$productOrderCtrl.translations['antibody.pdp.commerceCard.promotion.promocode']}}: {{promo.promoCode}} {{promo.promoTitle}} {{promo.promoDescription}}. {{$productOrderCtrl.translations['antibody.pdp.commerceCard.promotion.learnmore']}}
产品信息
24061-1-AP
种属反应
宿主/亚型
分类
类型
抗原
偶联物
形式
浓度
规格
纯化类型
保存液
内含物
保存条件
运输条件
产品详细信息
Immunogen sequence: MALVSADSR IAELLTELHQ LIKQTQEERS RSEHNLVNIQ KTHERMQTEN KISPYYRTKL RGLYTTAKAD AEAECNILRK ALDKIAEIKS LLEERRIAAK IAGLYNDSEP PRKTMRRGVL MTLLQQSAMT LPLWIGKPGD KPPPLCGAIP ASGDYVARPG DKVAARVKAV DGDEQWILAE VVSYSHATNK YEVDDIDEEG KERHTLSRRR VIPLPQWKAN PETDPEALFQ KEQLVLALYP QTTCFYRALI HAPPQRPQDD YSVLFEDTSY ADGYSPPLNV AQRYVVACKE PKKK (1-293 aa encoded by BC011981)
靶标信息
CCDC101 is a subunit of 2 histone acetyltransferase complexes: the ADA2A -containing -TAF9 /PCAF acetylase (STAGA) complex. Both of these complexes contain either GCN5 or PCAF, which are paralogous acetyltransferases.
仅用于科研。不用于诊断过程。未经明确授权不得转售。
生物信息学
蛋白别名: coiled-coil domain containing 101; Coiled-coil domain-containing protein 101; SAGA complex-associated factor 29; SAGA-associated factor 29; SAGA-associated factor 29 homolog; unnamed protein product
基因别名: CCDC101; SGF29; STAF36; TDRD29
UniProt ID: (Human) Q96ES7
Entrez Gene ID: (Human) 112869